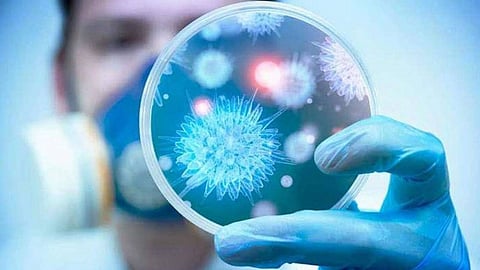

أعلنت وزارة الصحة، اليوم الأربعاء، عن تسجيل 1569 إصابة جديدة بفيروس كورونا المستجد (كوفيد-19)، في المملكة؛ ما يرفع إجمالي الإصابات إلى 293037، في حين بلغ إجمالي حالات التعافي 257269. ووصل العدد الإجمالي للوفيات بالفيروس إلى 3269 حالة، فيما تم تسجيل 36 حالة وفاة، و2151 حالة تعافٍ، خلال الـ24 ساعة الماضية.